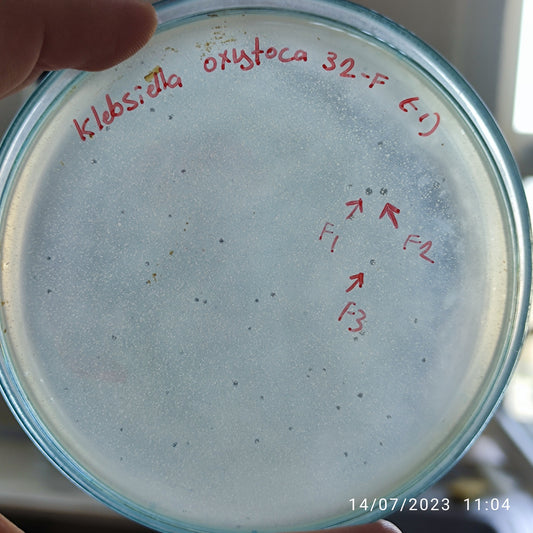
Klebsiella oxytoca bacteriophage 188032F
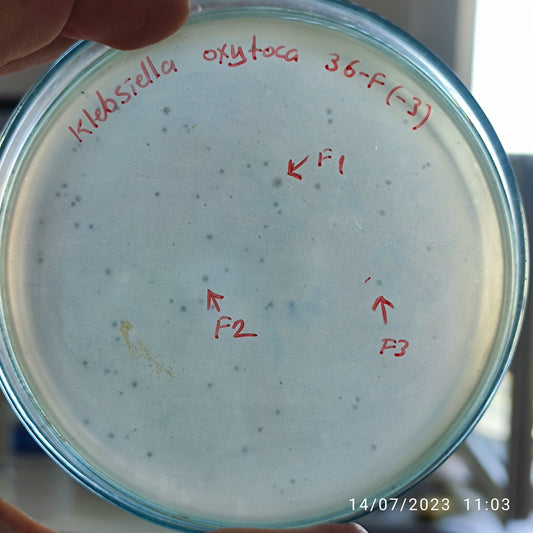
Klebsiella oxytoca bacteriophage 188036F
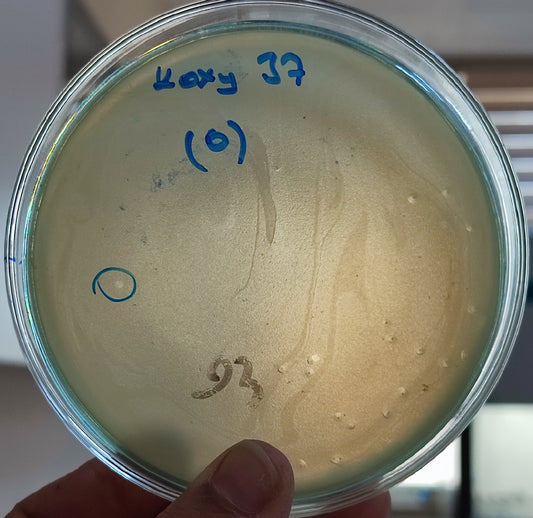
Klebsiella oxytoca bacteriophage 188037D
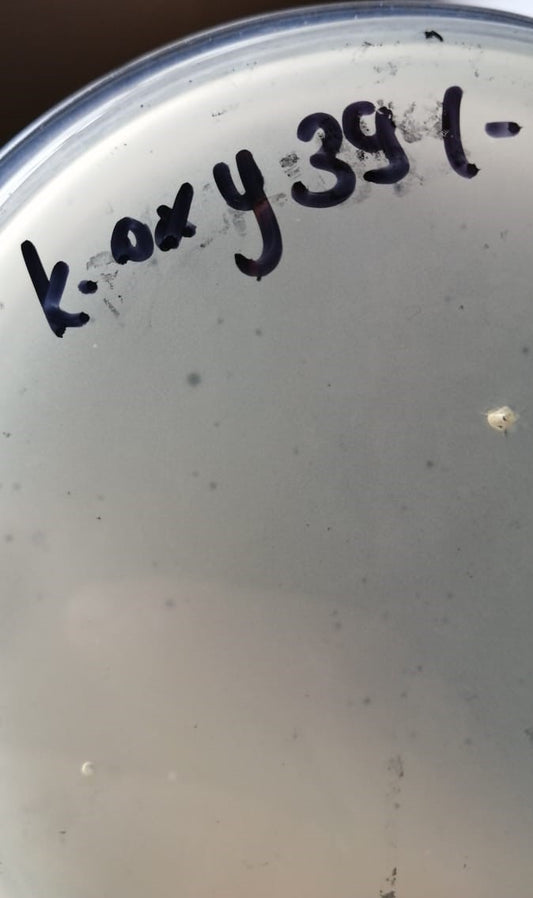
Klebsiella oxytoca bacteriophage 188039A
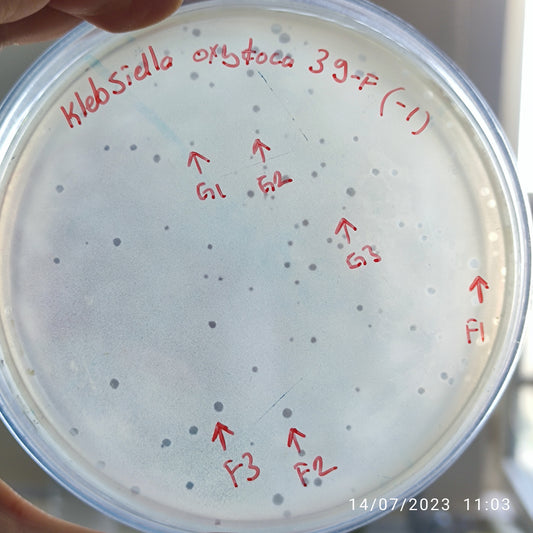
Klebsiella oxytoca bacteriophage 188039G
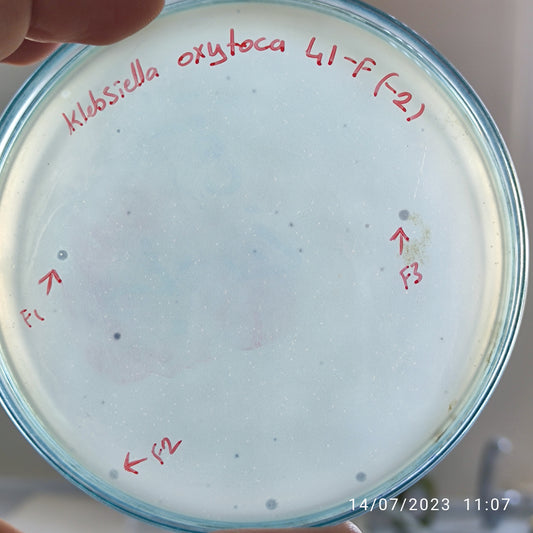
Klebsiella oxytoca bacteriophage 188041F
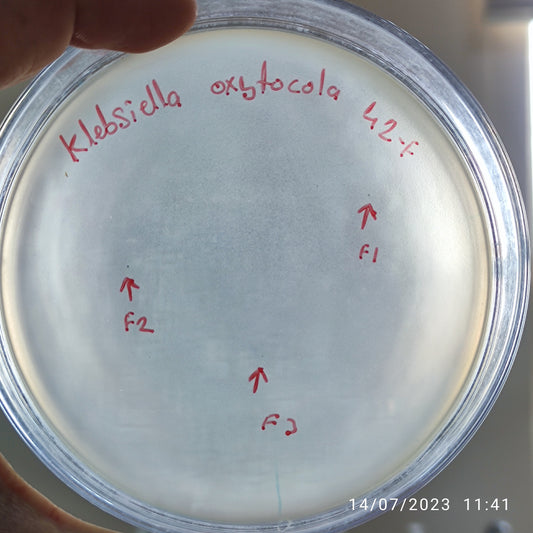
Klebsiella oxytoca bacteriophage 188042F
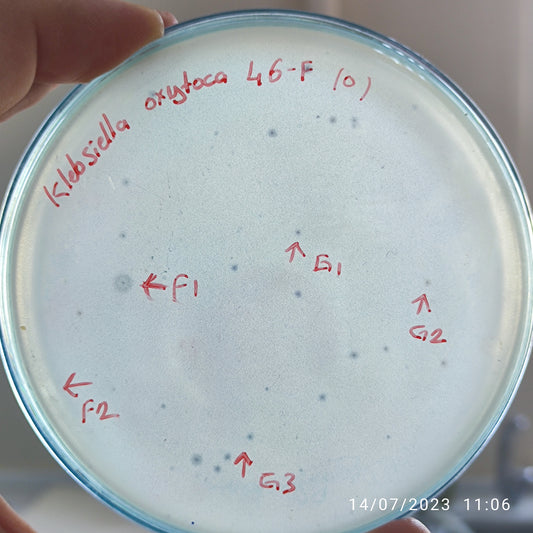
Klebsiella oxytoca bacteriophage 188046F

-
Klebsiella oxytoca bacteriophage 188032A
Regular price $750.00 USDRegular priceUnit price per -
Klebsiella oxytoca bacteriophage 188032F
Regular price $950.00 USDRegular priceUnit price per -
Klebsiella oxytoca bacteriophage 188036F
Regular price $875.00 USDRegular priceUnit price per -
Klebsiella oxytoca bacteriophage 188037D
Regular price $750.00 USDRegular priceUnit price per -
Klebsiella oxytoca bacteriophage 188038A
Regular price $750.00 USDRegular priceUnit price per -
Klebsiella oxytoca bacteriophage 188039A
Regular price $750.00 USDRegular priceUnit price per -
Klebsiella oxytoca bacteriophage 188039F
Regular price $900.00 USDRegular priceUnit price per -
Klebsiella oxytoca bacteriophage 188039G
Regular price $900.00 USDRegular priceUnit price per -
Klebsiella oxytoca bacteriophage 188040F
Regular price $750.00 USDRegular priceUnit price per -
Klebsiella oxytoca bacteriophage 188041A
Regular price $750.00 USDRegular priceUnit price per -
Klebsiella oxytoca bacteriophage 188041D
Regular price $750.00 USDRegular priceUnit price per -
Klebsiella oxytoca bacteriophage 188041F
Regular price $900.00 USDRegular priceUnit price per -
Klebsiella oxytoca bacteriophage 188042D
Regular price $750.00 USDRegular priceUnit price per -
Klebsiella oxytoca bacteriophage 188042F
Regular price $800.00 USDRegular priceUnit price per -
Klebsiella oxytoca bacteriophage 188046A
Regular price $750.00 USDRegular priceUnit price per -
Klebsiella oxytoca bacteriophage 188046F
Regular price $900.00 USDRegular priceUnit price per